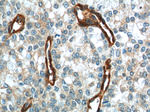
Vinculin Antibody in Immunohistochemistry (Paraffin) (IHC (P))

Search
Proteintech
Vinculin Monoclonal Antibody (2B5A7)
{{$productOrderCtrl.translations['antibody.pdp.commerceCard.promotion.promotions']}}
{{$productOrderCtrl.translations['antibody.pdp.commerceCard.promotion.viewpromo']}}
{{$productOrderCtrl.translations['antibody.pdp.commerceCard.promotion.promocode']}}: {{promo.promoCode}} {{promo.promoTitle}} {{promo.promoDescription}}. {{$productOrderCtrl.translations['antibody.pdp.commerceCard.promotion.learnmore']}}
产品信息
66305-1-IG
种属反应
已发表种属
宿主/亚型
分类
类型
克隆号
抗原
偶联物
形式
浓度
规格
纯化类型
保存液
内含物
保存条件
运输条件
产品详细信息
Immunogen sequence: PKFREAVKA ASDELSKTIS PMVMDAKAVA GNISDPGLQK SFLDSGYRIL GAVAKVREAF QPQEPDFPPP PPDLEQLRLT DELAPPKPPL PEGEVPPPRP PPPEEKDEEF PEQKAGEVIN QPMMMAARQL HDEARKWSSK GNDIIAAAKR MALLMAEMSR LVRGGSGTKR ALIQCAKDIA KASDEVTRLA KEVAKQCTDK RIRTNLLQVC ERIPTISTQL KILSTVKATM LGRTNISDEE SEQATEMLVH NAQNLMQSVK ETVREAEAAS IKIRTDAGFT LRWVRKTPWY Q (777-1066 aa encoded by BC039174)
靶标信息
Vinculin (VCL) is a cytoskeletal protein associated with cell-cell and cell-extracellular matrix adherens-type junctions. It functions as one of several interacting proteins involved in anchoring F-actin to the membrane. It has been shown that a sequence of molecular interactions might be involved in the transmembrane assembly of adhesion plaques. In the assembly of adhesion plaques, the beta subunit of integrin binds to talin. Talin binds to vinculin that interacts with alpha-actinin and possibly with itself. Since alpha-actinin binds to and cross-links actin filaments, vinculin represents a key element in the transmembrane linkage of the extracellular matrix to the cytoplasmic microfilament system. Mutations in the gene can result in cardiomyopathy dilated 1W or familial hypertrophic 15.
仅用于科研。不用于诊断过程。未经明确授权不得转售。
生物信息学
蛋白别名: epididymis luminal protein 114; epididymis secretory sperm binding protein; meta-vinculin; Metavinculin; metavinculin {ECO:0000250|UniProtKB:P18206}; MV; RP11-178G16.3; unnamed protein product; vcl {ECO:0000250|UniProtKB:P18206}; vinc; Vinculin; vinculin {ECO:0000250|UniProtKB:P18206}
基因别名: 9430097D22; AA571387; AI462105; AW545629; CMD1W; CMH15; HEL114; MV; MVCL; VCL; VIN; VINC
UniProt ID: (Human) P18206, (Pig) P26234, (Mouse) Q64727, (Rat) P85972
Entrez Gene ID: (Human) 7414, (Pig) 396974, (Mouse) 22330, (Rat) 305679